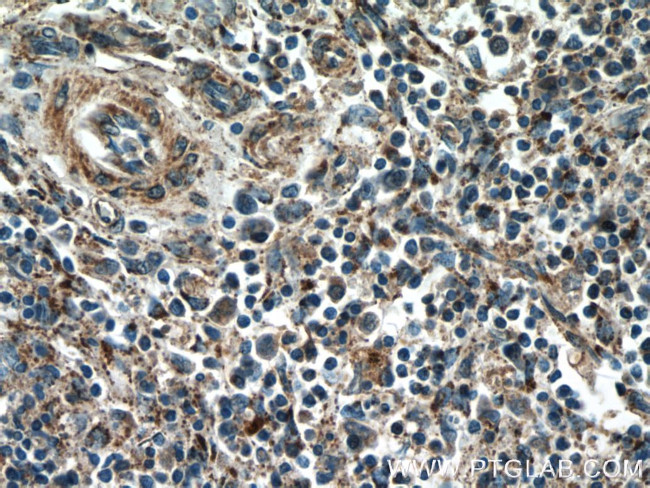
YOD1 Antibody in Immunohistochemistry (Paraffin) (IHC (P))

Search
Proteintech
YOD1 Polyclonal Antibody
{{$productOrderCtrl.translations['antibody.pdp.commerceCard.promotion.promotions']}}
{{$productOrderCtrl.translations['antibody.pdp.commerceCard.promotion.viewpromo']}}
{{$productOrderCtrl.translations['antibody.pdp.commerceCard.promotion.promocode']}}: {{promo.promoCode}} {{promo.promoTitle}} {{promo.promoDescription}}. {{$productOrderCtrl.translations['antibody.pdp.commerceCard.promotion.learnmore']}}
产品信息
25370-1-AP
种属反应
已发表种属
宿主/亚型
分类
类型
抗原
偶联物
形式
浓度
规格
纯化类型
保存液
内含物
保存条件
运输条件
产品详细信息
Immunogen sequence: LSSRTRVRE LQGQIAAITG IAPGGQRILV GYPPECLDLS NGDTILEDLP IQSGDMLIIE EDQTRPRSSP AFTKRGASSY VRETLPVLTR TVVPADNSCL FTSVYYVVEG GVLNPACAPE MRRLIAQIVA SDPDFYSEAI LGKTNQEYCD WIKRDDTWGG AIEISILSKF YQCEICVVDT QTVRIDRFGE DAGYTKRVLL IYDGIHYDPL QRNFPDPDTP PLTIFSSNDD IVLVQALELA DEARRRRQFT DVNRFTLRCM VCQKGLTGQA EAREHAKETG HTNFGEV (63-348 aa encoded by BC137167)
靶标信息
Deubiquitinating enzymes (DUBs) are proteases that specifically cleave ubiquitin linkages, negating the action of ubiquitin ligases. DUBA8 belongs to a DUB subfamily characterized by an ovarian tumor (OTU) domain.
仅用于科研。不用于诊断过程。未经明确授权不得转售。
生物信息学
蛋白别名: DUBA-8; HIN-7; HIV-1-induced protease 7; hsHIN7; OTU domain containing 2; OTU domain-containing protein 2; Ubiquitin thioesterase OTU1; unnamed protein product; YOD1 OTU deubiquinating enzyme 1 homolog ( yeast)
基因别名: DUBA-8; DUBA8; HIN-7; HIN7; OTUD2; PRO0907; YOD1
UniProt ID: (Human) Q5VVQ6
Entrez Gene ID: (Human) 55432